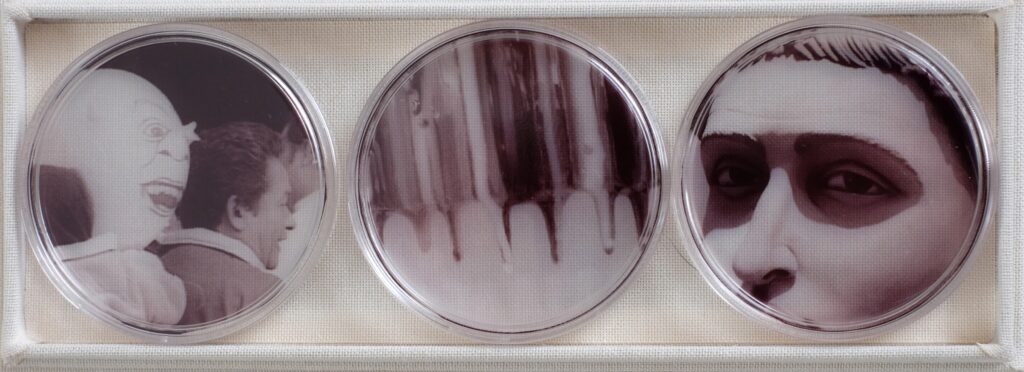
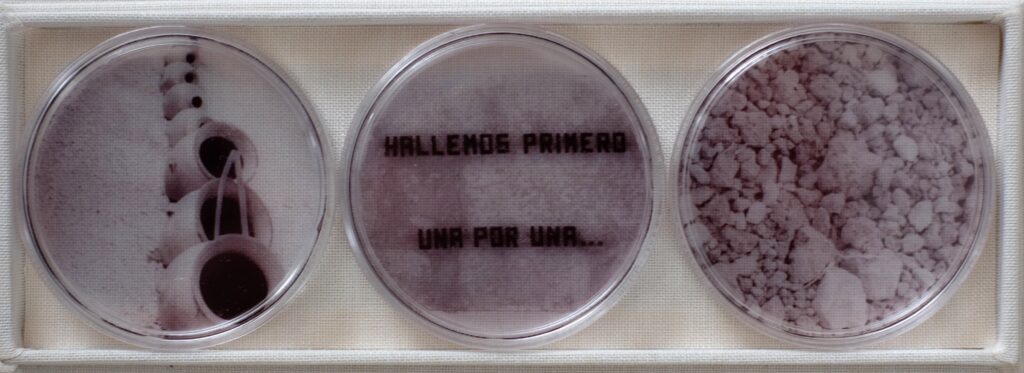

Lourdes Corzo
Vivo de aquello que los otros no saben de mí.
Peter Handke
Nos estamos vistiendo transparentes, pero la desnudez que mostramos es falsa, como si fuera un perchero donde elegimos lo que vamos a usar cada día; es una simulación.
Nuestra piel, nuestro cuerpo, va guardando la evidancia de los sucesos que nos han marcado. Las heridas dejan rastro, hacen marcas que se ven y otras que no se notan.
Nuestro cuerpo se convierte en soporte y territorio de vivencias donde cada cicatríz sanada ha dejado huella, que a manera de mapa va trazando caminos y conexiones, cruces y bifurcaciones individuales parecidas al kintsugi, dotando al sujeto del valor añadido que otorgan las batallas ganadas.
Esta dualidad que evoca el desgaste que obra sobre las cosas físicas y, por tanto, sobre el cuerpo humano al paso del tiempo produce decadencia, sin embargo, simultáneamente otorga valor a nuestras imperfecciones.
A veces, nuestros defectos son nuestras mayores virtudes.
Asi como el búho de Minerva que le muestra su mensaje cuando el día ha terminado, es decir, despues de una retrospectiva informada, así muestro los eventos que me han dejado huella, cuando cicatrizan y cuando están en proceso de hacerlo.
Las cicatrices causadas se insertan en nosotros en diferentes capas, de manera aristotélica lo hacen en razón, cuerpo y alma. Las represento con imágenes que van del exterior al interior en la realidad humana.
Un tema que debe ser visto de manera individual requiere una escala pequeña. Son secretos que guarda la piel. Lo que depositamos en el fondo es extremadamente débil y quebradizo y requerimos protegerlo.
Compuesta por un conjunto de estuches de acrílico, que evocan las cajas de Petri utilizadas para contener cultivos y analizar su evolución, presento series de tres piezas que muestran de manera metafórica los niveles de significación por capas hasta llegar a las más profundas, a través de imágenes fotográficas, texto y objetos.
Estas tres piezas de acrílico están contenidas por pequeñas cajas, cada una correspondiente a cada cicatriz. Algunas otras van solas y representan heridas no sanadas.
Como un mapa, las cajas están distribuidas sobre un plano, rodeadas por pequeños rollos de papel, cada uno conteniendo la historia de cada día de mi vida; ellas representan las diferentes etapas: tranquila o agitada, uniforme o desequilibrada.
Como esa forma que el tiempo encuentra de que
nunca olvidemos las heridas.
Piedad Bonnett